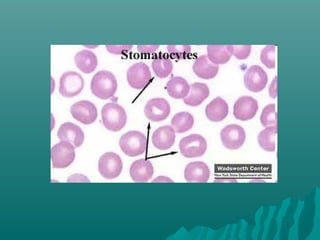
Peripheral smear
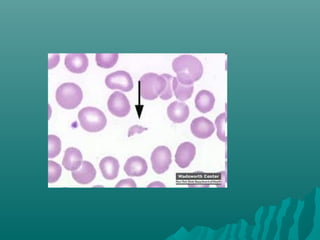
Peripheral smear
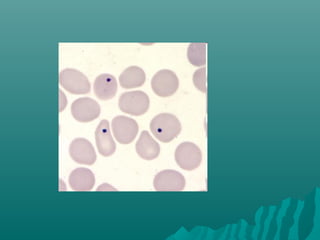
Peripheral smear
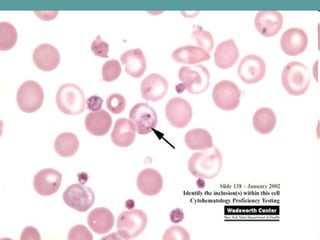
Peripheral smear
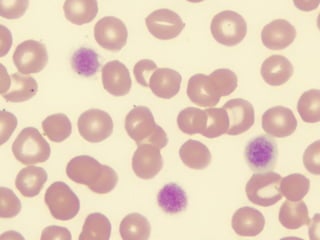
Peripheral smear

This document describes the different types of peripheral blood smears including wedge, spun, thick, buffy layer, and wet films. It discusses staining techniques like Leishman, Wright, and May-Grunwald Giemsa stains. Special stains are also covered such as peroxidase, Sudan Black B, PAS, and iron stains which can identify characteristics of cells and diseases. Proper preparation, fixation, and interpretation of peripheral blood smears is essential for hematological diagnosis and identification of abnormalities.